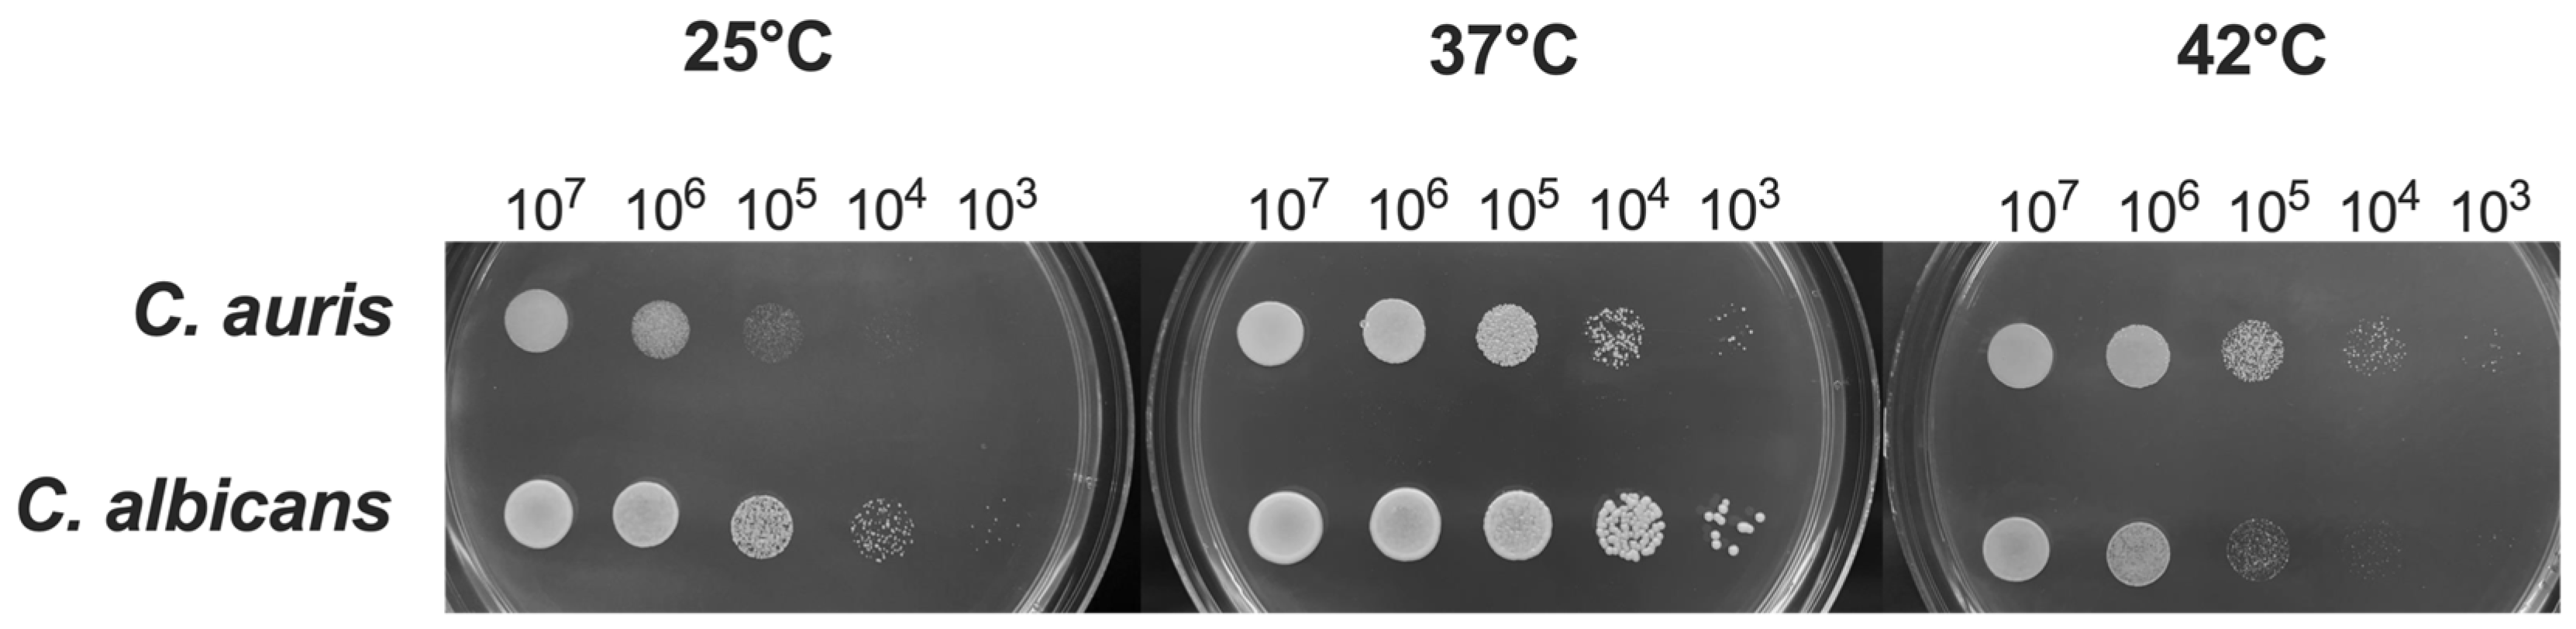
Jof 11 00625 g001
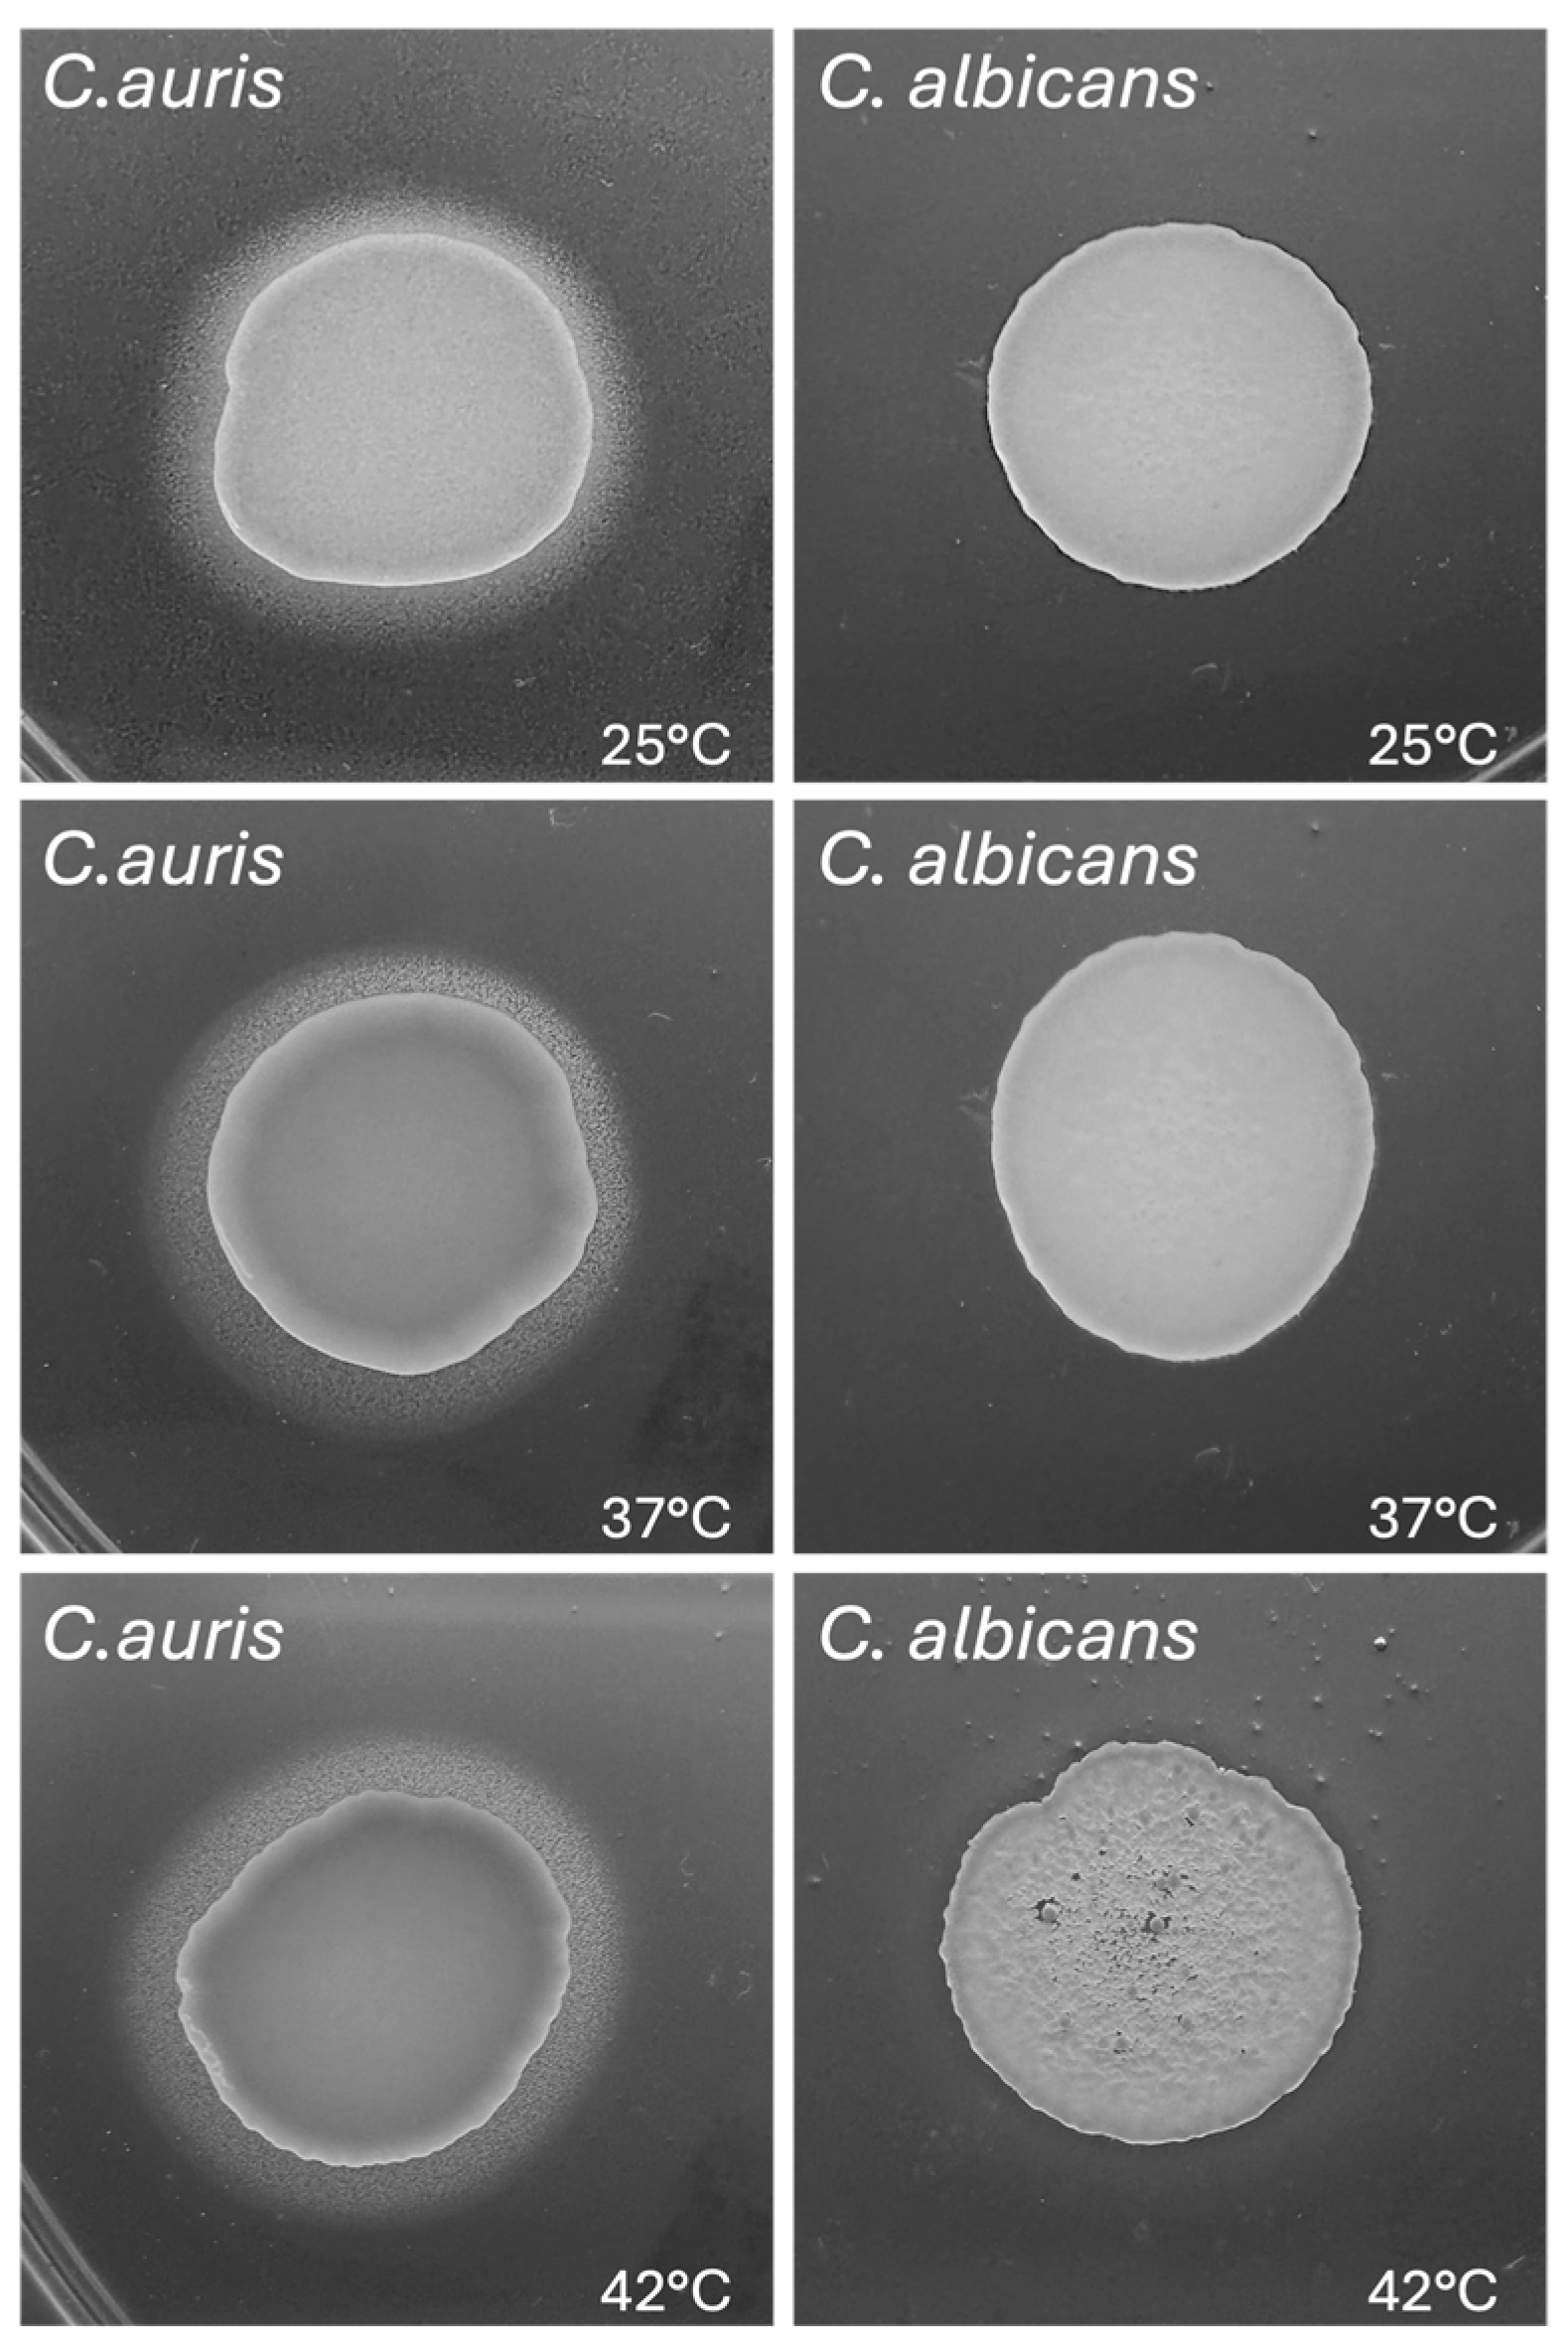
Jof 11 00625 g004

Biological Features, Antimicrobial Susceptibility and Phenotypic Characterization of Candidozyma auris CDC B11903 Grown at Different Temperatures
Abstract
1. Introduction
2. Materials and Methods
2.1. Candida Strains and Growth Conditions
2.2. Growth Determination
2.3. Antifungal Susceptibility Testing of C. auris CDC B11903
2.4. Melanin Production
2.5. Determination of Haemolytic Activity
2.6. Phospholipase Activity
2.7. Lipase Activity
2.8. Germ Tube Test
2.9. Filamentous Growth Assay
2.10. Biofilm Quantification by Crystal Violet and XTT Assays
2.11. Human Epithelial Cells and Infection Protocol
2.12. Adhesion onto Abiotic and Biotic Substrates
2.13. Statistical Analysis
3. Results
3.1. Impact of Temperature on C. auris Growth
3.2. Impact of Temperature on C. auris MIC
3.3. Impact of Temperature on C. auris Melanization
3.4. Impact of Temperature on C. auris Haemolytic Activity
3.5. Impact of Temperature on C. auris Phospholipase and Lipase Activity
3.6. Impact of Temperature on C. auris Germ Tube Formation
3.7. Impact of Temperature on C. auris Pseudohyphal Formation
3.8. Impact of Temperature on C. auris Biofilm Formation and Metabolic Activity
3.9. Adhesion Capacity of C. auris to Abiotic Surfaces and Epithelial Cells at Different Temperatures
4. Discussion
5. Conclusions
Supplementary Materials
Author Contributions
Funding
Institutional Review Board Statement
Informed Consent Statement
Data Availability Statement
Acknowledgments
Conflicts of Interest
References
- Guinea, J. Global Trends in the Distribution of Candida Species Causing Candidemia. Clin. Microbiol. Infect. 2014, 20, 5–10. [Google Scholar] [CrossRef]
- Kean, R.; Brown, J.; Gulmez, D.; Ware, A.; Ramage, G. Candida Auris: A Decade of Understanding of an Enigmatic Pathogenic Yeast. J. Fungi 2020, 6, 30. [Google Scholar] [CrossRef]
- Rhodes, J.; Fisher, M.C. Global Epidemiology of Emerging Candida auris. Curr. Opin. Microbiol. 2019, 52, 84–89. [Google Scholar] [CrossRef] [PubMed]
- Jeffery-Smith, A.; Taori, S.K.; Schelenz, S.; Jeffery, K.; Johnson, E.M.; Borman, A.; Candida auris Incident Management Team; Manuel, R.; Brown, C.S. Candida auris: A Review of the Literature. Clin. Microbiol. Rev. 2018, 31, e00029-17. [Google Scholar] [CrossRef] [PubMed]
- Posteraro, B.; Cosio, T.; Torelli, R.; De Carolis, E.; Magrì, C.; Posteraro, P.; De Angelis, G.; Sanguinetti, M. Diagnostic and Clinical Management of Candida Auris Infections in Immunocompromised Patients. Expert Rev. Anti-Infect. Ther. 2025, 23, 561–570. [Google Scholar] [CrossRef]
- Chowdhary, A.; Sharma, C.; Meis, J.F. Candida Auris: A Rapidly Emerging Cause of Hospital-Acquired Multidrug-Resistant Fungal Infections Globally. PLoS Pathog. 2017, 13, e1006290. [Google Scholar] [CrossRef] [PubMed]
- Magrì, C.; De Carolis, E.; Ivagnes, V.; Di Pilato, V.; Spruijtenburg, B.; Marchese, A.; Meijer, E.F.J.; Chowdhary, A.; Sanguinetti, M. “CLADE-FINDER”: Candida auris Lineage Analysis Determination by Fourier Transform Infrared Spectroscopy and Artificial Neural Networks. Microorganisms 2024, 12, 2153. [Google Scholar] [CrossRef] [PubMed]
- Watkins, R.R.; Gowen, R.; Lionakis, M.; Ghannoum, M. Update on the Pathogenesis, Virulence, and Treatment of Candida auris. Pathog. Immun. 2022, 7, 46–65. [Google Scholar] [CrossRef]
- Maphanga, T.G.; Naicker, S.D.; Kwenda, S.; Muñoz, J.F.; Van Schalkwyk, E.; Wadula, J.; Nana, T.; Ismail, A.; Coetzee, J.; Govind, C.; et al. In Vitro Antifungal Resistance of Candida auris Isolates from Bloodstream Infections, South Africa. Antimicrob. Agents Chemother. 2021, 65, e00517-21. [Google Scholar] [CrossRef] [PubMed]
- Khan, T.; Faysal, N.I.; Hossain, M.M.; Mah-E-Muneer, S.; Haider, A.; Moon, S.B.; Sen, D.; Ahmed, D.; Parnell, L.A.; Jubair, M.; et al. Emergence of the Novel Sixth Candida Auris Clade VI in Bangladesh. Microbiol. Spectr. 2024, 12, e03540-23. [Google Scholar] [CrossRef]
- Suphavilai, C.; Ko, K.K.K.; Lim, K.M.; Tan, M.G.; Boonsimma, P.; Chu, J.J.K.; Goh, S.S.; Rajandran, P.; Lee, L.C.; Tan, K.Y.; et al. Detection and Characterisation of a Sixth Candida auris Clade in Singapore: A Genomic and Phenotypic Study. Lancet Microbe 2024, 5, 100878. [Google Scholar] [CrossRef] [PubMed]
- Welsh, R.M.; Sexton, D.J.; Forsberg, K.; Vallabhaneni, S.; Litvintseva, A. Insights into the Unique Nature of the East Asian Clade of the Emerging Pathogenic Yeast Candida auris. J. Clin. Microbiol. 2019, 57, e00007-19. [Google Scholar] [CrossRef]
- Jenull, S.; Tscherner, M.; Kashko, N.; Shivarathri, R.; Stoiber, A.; Chauhan, M.; Petryshyn, A.; Chauhan, N.; Kuchler, K. Transcriptome Signatures Predict Phenotypic Variations of Candida auris. Front. Cell. Infect. Microbiol. 2021, 11, 662563. [Google Scholar] [CrossRef]
- Kumar, D.; Banerjee, T.; Pratap, C.B.; Tilak, R. Itraconazole-Resistant Candida auris with Phospholipase, Proteinase and Hemolysin Activity from a Case of Vulvovaginitis. J. Infect Dev. Ctries 2015, 9, 435–437. [Google Scholar] [CrossRef] [PubMed]
- Larkin, E.; Hager, C.; Chandra, J.; Mukherjee, P.K.; Retuerto, M.; Salem, I.; Long, L.; Isham, N.; Kovanda, L.; Borroto-Esoda, K.; et al. The Emerging Pathogen Candida auris: Growth Phenotype, Virulence Factors, Activity of Antifungals, and Effect of SCY-078, a Novel Glucan Synthesis Inhibitor, on Growth Morphology and Biofilm Formation. Antimicrob. Agents Chemother. 2017, 61, e02396-16. [Google Scholar] [CrossRef]
- Smith, D.F.Q.; Mudrak, N.J.; Zamith-Miranda, D.; Honorato, L.; Nimrichter, L.; Chrissian, C.; Smith, B.; Gerfen, G.; Stark, R.E.; Nosanchuk, J.D.; et al. Melanization of Candida auris Is Associated with Alteration of Extracellular pH. J. Fungi 2022, 8, 1068. [Google Scholar] [CrossRef] [PubMed]
- Bohner, F.; Papp, C.; Gácser, A. The Effect of Antifungal Resistance Development on the Virulence of Candida Species. FEMS Yeast Res. 2022, 22, foac019. [Google Scholar] [CrossRef]
- Du, H.; Bing, J.; Hu, T.; Ennis, C.L.; Nobile, C.J.; Huang, G. Candida Auris: Epidemiology, Biology, Antifungal Resistance, and Virulence. PLoS Pathog. 2020, 16, e1008921. [Google Scholar] [CrossRef] [PubMed]
- Lockhart, S.R.; Etienne, K.A.; Vallabhaneni, S.; Farooqi, J.; Chowdhary, A.; Govender, N.P.; Colombo, A.L.; Calvo, B.; Cuomo, C.A.; Desjardins, C.A.; et al. Simultaneous Emergence of Multidrug-Resistant Candida auris on 3 Continents Confirmed by Whole-Genome Sequencing and Epidemiological Analyses. Clin. Infect. Dis. 2017, 64, 134–140. [Google Scholar] [CrossRef]
- Chow, N.A.; De Groot, T.; Badali, H.; Abastabar, M.; Chiller, T.M.; Meis, J.F. Potential Fifth Clade of Candida Auris, Iran, 2018. Emerg. Infect. Dis. 2019, 25, 1780–1781. [Google Scholar] [CrossRef]
- Robert, V.A.; Casadevall, A. Vertebrate Endothermy Restricts Most Fungi as Potential Pathogens. J. Infect. Dis. 2009, 200, 1623–1626. [Google Scholar] [CrossRef] [PubMed]
- Casadevall, A. Global Warming Could Drive the Emergence of New Fungal Pathogens. Nat. Microbiol. 2023, 8, 2217–2219. [Google Scholar] [CrossRef] [PubMed]
- Garcia-Solache, M.A.; Casadevall, A. Global Warming Will Bring New Fungal Diseases for Mammals. mBio 2010, 1, e00061-10. [Google Scholar] [CrossRef] [PubMed]
- Casadevall, A.; Kontoyiannis, D.P.; Robert, V. On the Emergence of Candida auris: Climate Change, Azoles, Swamps, and Birds. mBio 2019, 10, e01397-19. [Google Scholar] [CrossRef]
- Bottery, M.; Sedik, S.; Schwartz, I.; Hoenigl, M.; Van Rhijn, N. Climate Change: Shifting Boundaries of Fungal Disease in Europe and Beyond. Thorax 2025, thorax-2024-222168. [Google Scholar] [CrossRef]
- Kogut, M. Microbial Strategies of Adaptability. Trends Biochem. Sci. 1980, 5, 47–50. [Google Scholar] [CrossRef]
- Wani, A.K.; Akhtar, N.; Sher, F.; Navarrete, A.A.; Américo-Pinheiro, J.H.P. Microbial Adaptation to Different Environmental Conditions: Molecular Perspective of Evolved Genetic and Cellular Systems. Arch. Microbiol. 2022, 204, 144. [Google Scholar] [CrossRef]
- Brumfield, K.D.; Usmani, M.; Chen, K.M.; Gangwar, M.; Jutla, A.S.; Huq, A.; Colwell, R.R. Environmental Parameters Associated with Incidence and Transmission of Pathogenic Vibrio Spp. Environ. Microbiol. 2021, 23, 7314–7340. [Google Scholar] [CrossRef]
- Hellberg, R.S.; Chu, E. Effects of Climate Change on the Persistence and Dispersal of Foodborne Bacterial Pathogens in the Outdoor Environment: A Review. Crit. Rev. Microbiol. 2016, 42, 548–572. [Google Scholar] [CrossRef]
- Bernardo-Cravo, A.P.; Schmeller, D.S.; Chatzinotas, A.; Vredenburg, V.T.; Loyau, A. Environmental Factors and Host Microbiomes Shape Host–Pathogen Dynamics. Trends Parasitol. 2020, 36, 616–633. [Google Scholar] [CrossRef]
- CLSI M27M44S; Performance Standards for Antifungal Susceptibility Testing of Yeasts. CLSI: Malvern, PA, USA, 2022.
- CDC. C. auris—Antifungal Susceptibility Testing and Interpretation; CDC: Atlanta, GA, USA, 2024.
- Luo, G.; Samaranayake, L.P.; Yau, J.Y. Candida Species Exhibit Differential in Vitro Hemolytic Activities. J. Clin. Microbiol. 2001, 39, 2971–2974. [Google Scholar] [CrossRef] [PubMed]
- Price, M.F.; Wilkinson, I.D.; Gentry, L.O. Plate Method for Detection of Phospholipase Activity in Candida albicans. Med. Mycol. 1982, 20, 7–14. [Google Scholar] [CrossRef] [PubMed]
- Slifkin, M. Tween 80 Opacity Test Responses of Various Candida Species. J. Clin. Microbiol. 2000, 38, 4626–4628. [Google Scholar] [CrossRef] [PubMed]
- Angiolella, L.; Rojas, F.; Giammarino, A.; Bellucci, N.; Giusiano, G. Identification of Virulence Factors in Isolates of Candida Haemulonii, Candida Albicans and Clavispora Lusitaniae with Low Susceptibility and Resistance to Fluconazole and Amphotericin B. Microorganisms 2024, 12, 212. [Google Scholar] [CrossRef]
- Walsh, T.J.; Hayden, R.T.; Larone, D.H. Larone’s Medically Important Fungi: A Guide to Identification; ASM Press: Washington, DC, USA, 2018; ISBN 978-1-68367-053-7. [Google Scholar]
- Pistoia, E.S.; Cosio, T.; Campione, E.; Pica, F.; Volpe, A.; Marino, D.; Di Francesco, P.; Monari, C.; Fontana, C.; Favaro, M.; et al. All-Trans Retinoic Acid Effect on Candida Albicans Growth and Biofilm Formation. J. Fungi 2022, 8, 1049. [Google Scholar] [CrossRef]
- Ben-Ami, R.; Berman, J.; Novikov, A.; Bash, E.; Shachor-Meyouhas, Y.; Zakin, S.; Maor, Y.; Tarabia, J.; Schechner, V.; Adler, A.; et al. Multidrug-Resistant Candida Haemulonii and C. Auris, Tel Aviv, Israel. Emerg. Infect. Dis. 2017, 23. [Google Scholar] [CrossRef]
- Ghannoum, M.A. Potential Role of Phospholipases in Virulence and Fungal Pathogenesis. Clin. Microbiol. Rev. 2000, 13, 122–143. [Google Scholar] [CrossRef]
- Bravo Ruiz, G.; Ross, Z.K.; Gow, N.A.R.; Lorenz, A. Pseudohyphal Growth of the Emerging Pathogen Candida auris Is Triggered by Genotoxic Stress through the S Phase Checkpoint. mSphere 2020, 5, e00151-20. [Google Scholar] [CrossRef]
- Chow, E.W.L.; Pang, L.M.; Wang, Y. From Jekyll to Hyde: The Yeast–Hyphal Transition of Candida Albicans. Pathogens 2021, 10, 859. [Google Scholar] [CrossRef]
- Denham, S.T.; Wambaugh, M.A.; Brown, J.C.S. How Environmental Fungi Cause a Range of Clinical Outcomes in Susceptible Hosts. J. Mol. Biol. 2019, 431, 2982–3009. [Google Scholar] [CrossRef] [PubMed]
- Hube, B. Fungal Adaptation to the Host Environment. Curr. Opin. Microbiol. 2009, 12, 347–349. [Google Scholar] [CrossRef]
- Borman, A.M.; Szekely, A.; Johnson, E.M. Comparative Pathogenicity of United Kingdom Isolates of the Emerging Pathogen Candida Auris and Other Key Pathogenic Candida Species. mSphere 2016, 1, e00189-16. [Google Scholar] [CrossRef]
- Chaabane, F.; Graf, A.; Jequier, L.; Coste, A.T. Review on Antifungal Resistance Mechanisms in the Emerging Pathogen Candida auris. Front. Microbiol. 2019, 10, 2788. [Google Scholar] [CrossRef] [PubMed]
- Forsberg, K.; Woodworth, K.; Walters, M.; Berkow, E.L.; Jackson, B.; Chiller, T.; Vallabhaneni, S. Candida Auris: The Recent Emergence of a Multidrug-Resistant Fungal Pathogen. Med. Mycol. 2019, 57, 1–12. [Google Scholar] [CrossRef] [PubMed]
- Zheng, L.; Xu, Y.; Wang, C.; Yang, F.; Dong, Y.; Guo, L. Susceptibility to Caspofungin Is Regulated by Temperature and Is Dependent on Calcineurin in Candida albicans. Microbiol. Spectr. 2023, 11, e01790-23. [Google Scholar] [CrossRef] [PubMed]
- Chen, X.-F.; Zhang, H.; Liu, L.-L.; Guo, L.-N.; Liu, W.-J.; Liu, Y.-L.; Li, D.-D.; Zhao, Y.; Zhu, R.-Y.; Li, Y.; et al. Genome-Wide Analysis of in Vivo-Evolved Candida auris Reveals Multidrug-Resistance Mechanisms. Mycopathologia 2024, 189, 35. [Google Scholar] [CrossRef]
- Khan, Z.; Ahmad, S.; Al-Sweih, N.; Joseph, L.; Alfouzan, W.; Asadzadeh, M. Increasing Prevalence, Molecular Characterization and Antifungal Drug Susceptibility of Serial Candida auris Isolates in Kuwait. PLoS ONE 2018, 13, e0195743. [Google Scholar] [CrossRef]
- Rosenberg, A.; Ene, I.V.; Bibi, M.; Zakin, S.; Segal, E.S.; Ziv, N.; Dahan, A.M.; Colombo, A.L.; Bennett, R.J.; Berman, J. Antifungal Tolerance Is a Subpopulation Effect Distinct from Resistance and Is Associated with Persistent Candidemia. Nat. Commun. 2018, 9, 2470. [Google Scholar] [CrossRef]
- Boucherit, Z.; Boucherit, Z.; Seksek, O.; Bolard, J. Dormancy of Candida Albicans Cells in the Presence of the Polyene Antibiotic Amphotericin B: Simple Demonstration by Flow Cytometry. Med. Mycol. 2007, 45, 525–533. [Google Scholar] [CrossRef]
- Kang, M.; Choi, T.-R.; Ahn, S.; Heo, H.Y.; Kim, H.; Lee, H.S.; Lee, Y.K.; Joo, H.-S.; Yune, P.S.; Kim, W.; et al. Arctic Psychrotolerant Pseudomonas Sp. B14-6 Exhibits Temperature-Dependent Susceptibility to Aminoglycosides. Antibiotics 2022, 11, 1019. [Google Scholar] [CrossRef]
- Pfaller, M.A.; Burmeister, L.; Bartlett, M.S.; Rinaldi, M.G. Multicenter Evaluation of Four Methods of Yeast Inoculum Preparation. J. Clin. Microbiol. 1988, 26, 1437–1441. [Google Scholar] [CrossRef]
- Tahoun, M.K.; Shata, O.H.; Mashalley, R.I.; Abou-Domia, S.A. Influence of Selected Sugars and Temperature on Fatty Acids Composition in Candida Tropicalis. Nahrung 1988, 32, 327–333. [Google Scholar] [CrossRef]
- Boiron, P.; Drouhet, E.; Dupont, B.; Improvisi, L. Entry of Ketoconazole into Candida Albicans. Antimicrob. Agents Chemother. 1987, 31, 244–248. [Google Scholar] [CrossRef] [PubMed]
- García, M.T.; Llorente, M.T.; Mínguez, F.; Prieto, J. Influence of Temperature and Concentration on the Postantifungal Effect and the Effects of Sub-MIC Concentrations of Four Antifungal Agents on Previously Treated Candida Species. Chemotherapy 2000, 46, 245–252. [Google Scholar] [CrossRef] [PubMed]
- Money, N.P. Fungal Thermotolerance Revisited and Why Climate Change Is Unlikely to Be Supercharging Pathogenic Fungi (Yet). Fungal Biol. 2024, 128, 1638–1641. [Google Scholar] [CrossRef] [PubMed]
- Zhang, F.; Aschenbrenner, D.; Yoo, J.Y.; Zuo, T. The Gut Mycobiome in Health, Disease, and Clinical Applications in Association with the Gut Bacterial Microbiome Assembly. Lancet Microbe 2022, 3, e969–e983. [Google Scholar] [CrossRef]
- Jacobson, E.S.; Tinnell, S.B. Antioxidant Function of Fungal Melanin. J. Bacteriol. 1993, 175, 7102–7104. [Google Scholar] [CrossRef]
- Alviano, D.S.; Franzen, A.J.; Travassos, L.R.; Holandino, C.; Rozental, S.; Ejzemberg, R.; Alviano, C.S.; Rodrigues, M.L. Melanin from Fonsecaea Pedrosoi Induces Production of Human Antifungal Antibodies and Enhances the Antimicrobial Efficacy of Phagocytes. Infect. Immun. 2004, 72, 229–237. [Google Scholar] [CrossRef]
- Doering, T.L.; Nosanchuk, J.D.; Roberts, W.K.; Casadevall, A. Melanin as a Potential Cryptococcal Defence against Microbicidal Proteins. Med. Mycol. 1999, 37, 175–181. [Google Scholar] [CrossRef]
- Rosas, Á.L.; Casadevall, A. Melanization Decreases the Susceptibility of Cryptococcus Neoformans to Enzymatic Degradation. Mycopathologia 2001, 151, 53–56. [Google Scholar] [CrossRef]
- Carvajal, S.K.; Alvarado, M.; Rodríguez, Y.M.; Parra-Giraldo, C.M.; Varón, C.; Morales-López, S.E.; Rodríguez, J.Y.; Gómez, B.L.; Escandón, P. Pathogenicity Assessment of Colombian Strains of Candida auris in the Galleria Mellonella Invertebrate Model. J. Fungi 2021, 7, 401. [Google Scholar] [CrossRef] [PubMed]
- Naglik, J.R.; Challacombe, S.J.; Hube, B. Candida Albicans Secreted Aspartyl Proteinases in Virulence and Pathogenesis. Microbiol. Mol. Biol. Rev. 2003, 67, 400–428. [Google Scholar] [CrossRef] [PubMed]
- Kean, R.; Delaney, C.; Sherry, L.; Borman, A.; Johnson, E.M.; Richardson, M.D.; Rautemaa-Richardson, R.; Williams, C.; Ramage, G. Transcriptome Assembly and Profiling of Candida Auris Reveals Novel Insights into Biofilm-Mediated Resistance. mSphere 2018, 3, e00334-18. [Google Scholar] [CrossRef] [PubMed]
- Wang, X.; Bing, J.; Zheng, Q.; Zhang, F.; Liu, J.; Yue, H.; Tao, L.; Du, H.; Wang, Y.; Wang, H.; et al. The First Isolate of Candida Auris in China: Clinical and Biological Aspects. Emerg. Microbes Infect. 2018, 7, 1–9. [Google Scholar] [CrossRef]
- Sherry, L.; Ramage, G.; Kean, R.; Borman, A.; Johnson, E.M.; Richardson, M.D.; Rautemaa-Richardson, R. Biofilm-Forming Capability of Highly Virulent, Multidrug-Resistant Candida auris. Emerg. Infect. Dis. 2017, 23, 328–331. [Google Scholar] [CrossRef]
- Rossato, L.; Colombo, A.L. Candida Auris: What Have We Learned About Its Mechanisms of Pathogenicity? Front. Microbiol. 2018, 9, 3081. [Google Scholar] [CrossRef]
- Gulati, M.; Nobile, C.J. Candida Albicans Biofilms: Development, Regulation, and Molecular Mechanisms. Microbes Infect. 2016, 18, 310–321. [Google Scholar] [CrossRef]

| Temperature | 25 °C | 37 °C | 42 °C |
|---|---|---|---|
| Amphotericin B | 0.50 μg/mL | 1.00 μg/mL | 1.00 μg/mL |
| Fluconazole | 4.00 μg/mL | 8.00 μg/mL | 8.00 μg/mL |
| Isavuconazole | 0.008 μg/mL | 0.12 μg/mL | 0.12 μg/mL |
| Itraconazole | 0.03 μg/mL | 0.12 μg/mL | 0.12 μg/mL |
| Posaconazole | 0.015 μg/mL | 0.06 μg/mL | 0.06 μg/mL |
| Voriconazole | 0.015 μg/mL | 0.06 μg/mL | 0.06 μg/mL |
| Micafungin | 0.03 μg/mL | 0.06 μg/mL | 0.06 μg/mL |
| Anidulafungin | 0.06 μg/mL | 0.06 μg/mL | 0.12 μg/mL |
| Caspofungin | 0.06 μg/mL | 0.12 μg/mL | 0.12 μg/mL |
| Temperature | 25 °C | 37 °C | 42 °C | |||
|---|---|---|---|---|---|---|
| Hz | Categorization | Hz | Categorization | Hz | Categorization | |
| C. auris | 0.690 ± 0.073 | low | 0.46 ± 0.020 **** | moderate | 0.38 ± 0.003 #### | high |
| C. albicans | 0.376 ± 0.011 | high | 0.322 ± 0.036 | high | 0.251 ± 0.011 | high |
| Temperature | 25 °C | 37 °C | 42 °C | |||
|---|---|---|---|---|---|---|
| Pz | Categorization | Pz | Categorization | Pz | Categorization | |
| C. auris | 0. 780 ± 0.055 | moderate | 0.780 ± 0.063 | moderate | 0.770 ± 0.030 | moderate |
| C. albicans | 1 | none | 1 | none | 1 | none |
| Temperature | 25 °C | 37 °C | 42 °C | |||
|---|---|---|---|---|---|---|
| Lz Score | Categorization | Lz Score | Categorization | Lz Score | Categorization | |
| C. auris | 0.48 ± 0.014 | High | 0.72 ± 0.059 ### | Moderate | 0.71 ± 0.044 ### | Moderate |
| C. albicans | 0.46 ± 0.043 | High | 0.50 ± 0.113 | High | 1.00 ### | none |
| Temperature | Biofilm Biomass (OD 595 nm) | p-Value | Biofilm Metabolic Activity (OD 490 nm) | p-Value | |
|---|---|---|---|---|---|
| C. auris | 25 °C | 0.764 ± 0.234 | - | 0.580 ± 0.112 | - |
| 37 °C | 0.772 ± 0.236 | ns | 0.731 ± 0.083 | ** vs. 25 °C (p < 0.01) | |
| 42 °C | 0.749 ± 0.248 | ns | 0.614 ± 0.087 | * vs. 37 °C (p < 0.05) | |
| C. albicans | 25 °C | 0.889 ± 0.128 | - | 0.865 ± 0.173 | |
| 37 °C | 1.021 ± 0.125 | * vs 25 °C (p < 0.001) | 0.962 ± 0.173 | * vs. 25 °C (p < 0.05) | |
| 42 °C | 1.019 ± 0.126 | * vs. 25 °C (p < 0.001) | 0.932 ± 0.173 | * vs. 25 °C (p < 0.05) |
Disclaimer/Publisher’s Note: The statements, opinions and data contained in all publications are solely those of the individual author(s) and contributor(s) and not of MDPI and/or the editor(s). MDPI and/or the editor(s) disclaim responsibility for any injury to people or property resulting from any ideas, methods, instructions or products referred to in the content. |
© 2025 by the authors. Licensee MDPI, Basel, Switzerland. This article is an open access article distributed under the terms and conditions of the Creative Commons Attribution (CC BY) license (https://creativecommons.org/licenses/by/4.0/).
Share and Cite
Cosio, T.; Pedretti, N.; Spaggiari, L.; Tordelli Ruda, L.; Kenno, S.; Sabbatini, S.; Pistoia, E.S.; Comar, M.; Monari, C.; Ardizzoni, A.; et al. Biological Features, Antimicrobial Susceptibility and Phenotypic Characterization of Candidozyma auris CDC B11903 Grown at Different Temperatures. J. Fungi 2025, 11, 625. https://doi.org/10.3390/jof11090625
Cosio T, Pedretti N, Spaggiari L, Tordelli Ruda L, Kenno S, Sabbatini S, Pistoia ES, Comar M, Monari C, Ardizzoni A, et al. Biological Features, Antimicrobial Susceptibility and Phenotypic Characterization of Candidozyma auris CDC B11903 Grown at Different Temperatures. Journal of Fungi. 2025; 11(9):625. https://doi.org/10.3390/jof11090625
Chicago/Turabian StyleCosio, Terenzio, Natalia Pedretti, Luca Spaggiari, Luigi Tordelli Ruda, Samyr Kenno, Samuele Sabbatini, Enrico Salvatore Pistoia, Manola Comar, Claudia Monari, Andrea Ardizzoni, and et al. 2025. "Biological Features, Antimicrobial Susceptibility and Phenotypic Characterization of Candidozyma auris CDC B11903 Grown at Different Temperatures" Journal of Fungi 11, no. 9: 625. https://doi.org/10.3390/jof11090625
APA StyleCosio, T., Pedretti, N., Spaggiari, L., Tordelli Ruda, L., Kenno, S., Sabbatini, S., Pistoia, E. S., Comar, M., Monari, C., Ardizzoni, A., Gaziano, R., & Pericolini, E. (2025). Biological Features, Antimicrobial Susceptibility and Phenotypic Characterization of Candidozyma auris CDC B11903 Grown at Different Temperatures. Journal of Fungi, 11(9), 625. https://doi.org/10.3390/jof11090625

